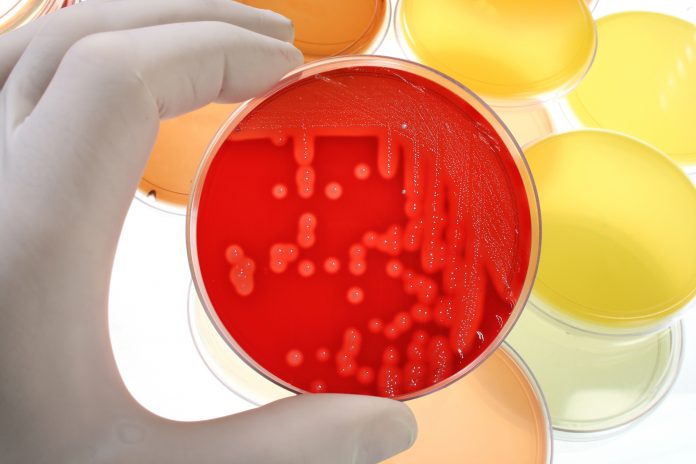

Streszczenie
Świadomość na temat możliwych zagrożeń epidemiologicznych w gabinetach kosmetycznych w ostatnich latach znacznie wzrosła. Jest to zasługa zarówno właścicieli, jak i pracowników salonów, którzy wprowadzają nowe wymogi z zakresu dezynfekcji, sterylizacji oraz higieny.
Celem pracy było przedstawienie niebezpiecznych i szkodliwych czynników, często zagrażających życiu oraz zdrowiu, na jakie są narażeni są pracownicy i klienci gabinetów kosmetycznych.
Do najczęstszych zakażeń krwiopochodnych dochodzi na skutek bezpośredniego kontaktu zakażonej krwi z ranami lub nawet niewielkimi uszkodzeniami skóry oraz błonami śluzowymi. Ze względu na dość liczne zagrożenia biologiczne, pracownicy powinni stosować sprzęt jednorazowego użytku oraz narzędzia, poddawane wcześniej zabiegowi sterylizacji. Podstawowe zasady, których powinno się przestrzegać, to odpowiednia dezynfekcja, mycie oraz sterylizacja.
Słowa kluczowe: zagrożenia mikrobiologiczne, gabinet kosmetyczny, higiena, zakażenie, sterylizacja, dezynfekcja, postępowanie, procedury
Microbiology threats in beauty parlours
Abstract
The awareness of possible epidemiological threats encountered in beauty salons have increased significantly over the last few years. This is due to both the owners and employees of those salons, who introduce new requirements in the field of disinfection, sterilization and hygiene.
The aim of this paper was to present hazardous and harmful factors endangering human life and health that threaten employees and clients of beauty parlours.
The most frequent blood-borne infections occur due to direct contact of infected blood with wounds or even minor damage to the skin and mucous membranes. Considering rather common biological threats, employees should use disposable equipment and presterilised tools. Basic principles to follow are: appropriate disinfection, cleaning and sterilisation.
Key words: microbiological threats, beauty parlour, hygiene, infection, sterilization, disinfection, course of actions, procedures
Marta Bednarek, Marzena Podgórska
Wydział Fizjoterapii i Nauk o Zdrowiu
Wyższa Szkoła Zarządzania w Gdańsku
ul. Pelplińska 7
80-335 Gdańsk
M: +48 609 200 346
E: marta.bednarek@wsz.pl
Czytaj całość: Kosmetologia Estetyczna, vol. 7(4), 2018, 477